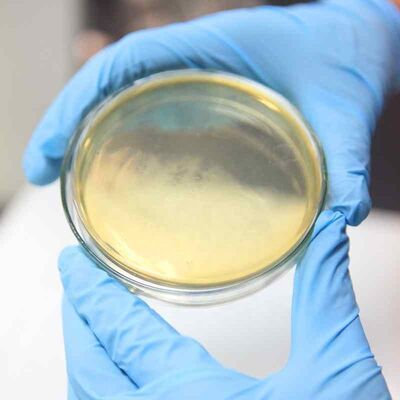

اترك رسالة
 يجب أن تكون رسالتك بين 20-3000 حرف!
يجب أن تكون رسالتك بين 20-3000 حرف!
 من فضلك تفقد بريدك الالكتروني!
من فضلك تفقد بريدك الالكتروني!
إرسال
مزيد من المعلومات يسهل التواصل بشكل أفضل.
سيد
- سيد
- السيدة
حسنا
تم الإرسال بنجاح!
حسنا
اترك رسالة
 يجب أن تكون رسالتك بين 20-3000 حرف!
يجب أن تكون رسالتك بين 20-3000 حرف!
 من فضلك تفقد بريدك الالكتروني!
من فضلك تفقد بريدك الالكتروني!
إرسال